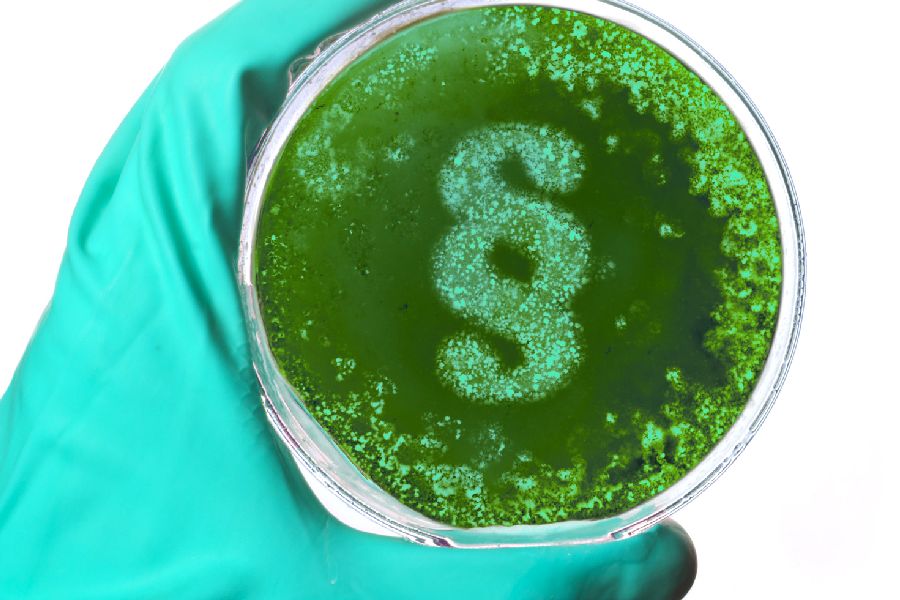
per Klick gelangen Sie zur Seite Infektionsschutz. Hand im Handschuh mit Petrischale

Durch eine regelmäßige und umfassende Gefährdungsbeurteilung können schulische Einrichtungen ein sicheres und gesundes Arbeitsumfeld schaffen und die Zahl der Arbeitsunfälle und Gesundheitsschäden reduzieren. Gefährdungen und Risiken für Gesundheit und Sicherheit aller Beschäftigten werden erkannt und möglichst gering gehalten.